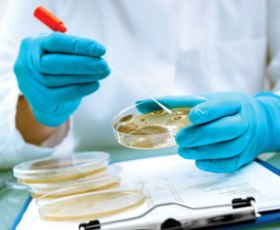

28
Aprile
2026
Accademia di San Luca,
Piazza Accademia di San Luca 77
Roma, 00187 Italia
+ Google MapsRoma, 00187 Italia
28
Aprile
2026
Palazzo Wedekind,
Piazza Colonna 366
Roma, 00187 Italia
+ Google MapsRoma, 00187 Italia
14
Maggio
2026
Biblioteca nazionale centrale di Roma,
viale Castro Pretorio 105
Roma, 00185 Italia
+ Google MapsRoma, 00185 Italia